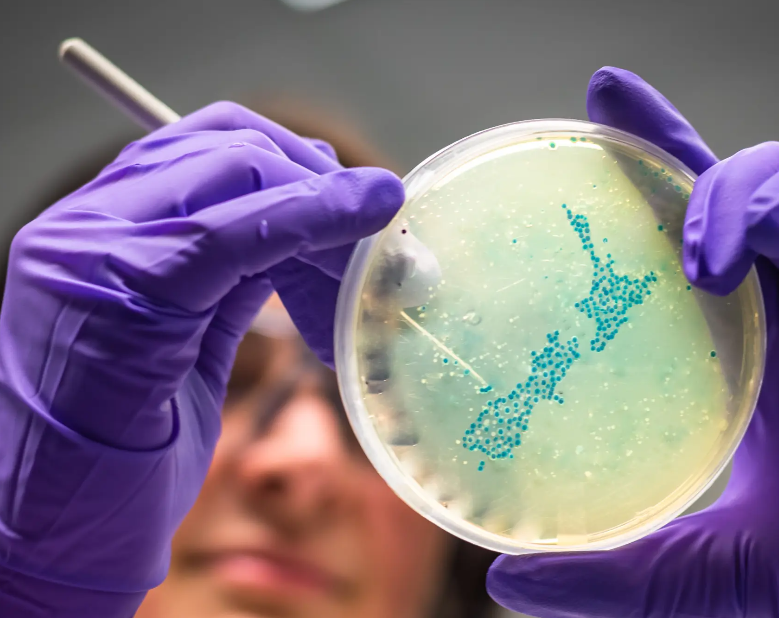
ScreenShot_2025-11-06_082646_948.png

投入7500万纽币!新西兰升级传染病防御体系
作者: Carl 日期:2025-11-06 13:28 阅读:0 来源:天维网报道
【天维网综合报道】新西兰政府宣布投入7500万纽币建立传染病研究平台,通过长达七年的持续资助强化公共卫生应急体系,该平台将由新成立的公共卫生与法医科学研究所负责运营。
Source:phcc
新西兰科学、创新与技术部长Dr Shane Reti宣布,政府将投入7500万纽币资金,用于提升新西兰对传染病的抵御能力及疫情防范水平。
“我们将通过传染病研究平台开展为期七年半的新研究,该平台将由新成立的新西兰公共卫生与法医科学研究所(PHF Science)负责运营。”
“当前新西兰正面临麻疹疫情爆发——这种疾病本可通过疫苗预防——这凸显了我们建立强大传染病研究与响应体系的迫切需求。”
“新平台将在原有传染病研究计划Te Niwha基础上进行升级。通过国家协调体系与长期投资来提供世界级科研成果,这标志着我们应对疫情的准备和响应方式实现了阶跃式发展。”Reti部长称。
该平台将实现以下目标:
- 深化疫情防范与应对能力,包括应急科研产能建设;
- 降低新西兰受未来疫情损害的影响程度,保护经济、劳动力、医疗系统和社区;
- 构建战略性、敏捷性且整合的研究响应体系,能够适应新的优先事项并交付具有影响力的科研成果;
- 支持突破性研究,以减轻风湿热、结核病和脑膜炎等现有疾病带来的负担。
Reti部长指出:“该研究所完全有能力领导全国性传染病研究,确保新西兰未来能更好地预防和管理这类破坏性疾病。”
“此项投资体现了政府对科技体系改革的承诺,通过支持长期任务导向型研究,在关键领域产生实质影响。”Reti补充说。
版权声明
1. 未经《新西兰天维网》书面许可,对于《新西兰天维网》拥有版权、编译和/或其他知识产权的任何内容,任何人不得复制、转载、摘编或在非《新西兰天维网》所属的服务器上做镜像或以其他任何方式进行使用,否则将追究法律责任。
2. 在《新西兰天维网》上转载的新闻,版权归新闻原信源所有,新闻内容并不代表本网立场。
版权声明
1.
未经《新西兰天维网》书面许可,对于《新西兰天维网》拥有版权、编译和/或其他知识产权的任何内容,任何人不得复制、转载、摘编或在非《新西兰天维网》所属的服务器上做镜像或以其他任何方式进行使用,否则将追究法律责任。
2. 在《新西兰天维网》上转载的新闻,版权归新闻原信源所有,新闻内容并不代表本网立场。
- 华人“黑马”助NZ国家党赢关键选区 将成国会议员
- 送电影票啦!7月26日“中国第一神探”归来,超大屏幕IMAX实力诠释狄仁杰风采!
- 新西兰中央政府协调员日薪1654纽币,纳税人“肉疼”
- 本周六新西兰强力球累积到$4000万 为史上第二大奖
- 新西兰工党承诺:若明年当选,将提供免费宫颈筛查
- 全国租金再次下滑,奥克兰一地降幅达超20%!
- 125年来首次!餐饮界“奥斯卡”登陆新西兰
- 今年夏天新西兰或将更为湿热
- 北岛怀卡托发生致命车祸 2人当场身亡
- 新西兰计划中的一项立法,将彻底“封杀”一类中国商品
· 请您文明上网、理性发言
· 尊重网上道德,承担一切因您的行为而直接或间接引起的法律责任
· 您的留言只代表个人意见,不代表本站立场
· 天维网拥有管理笔名和留言的一切权利
· 您在天维网留言板发表的言论,天维网有权在网站内转载或引用
· 天维网新闻留言板管理人员有权保留或删除其管辖留言中的任意内容
· 参与本留言即表明您已经阅读并接受上述条款
查看所有评论 共( 条)







